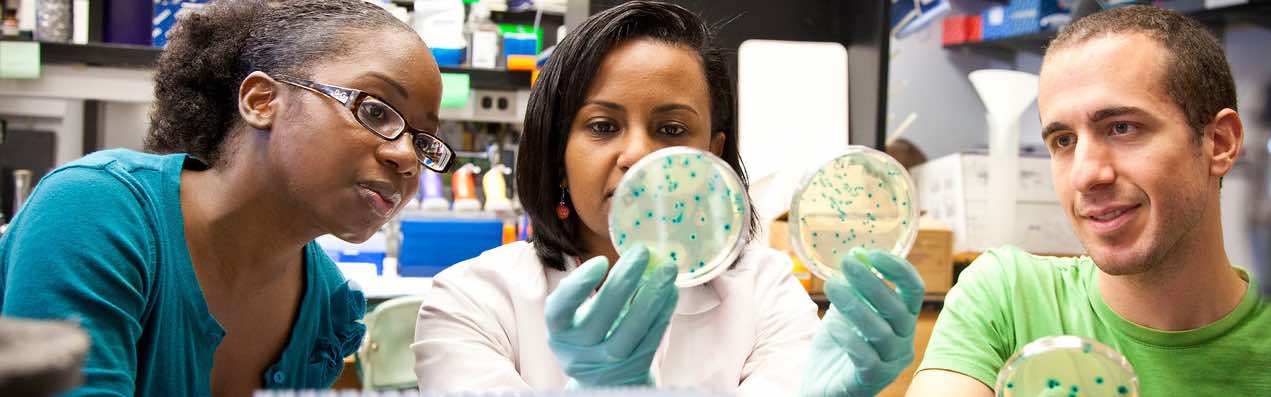

Graduate Division of Biological and Biomedical Sciences at Emory University

Modern Multidisciplinary Training
The Graduate Division of Biological and Biomedical Sciences at Emory University provides our students with the opportunity to work with world-renowned researchers at Emory University, a leading biological research and medical referral center in the Southeast.
- Over 16,000 graduate, undergraduate and professional students.
- Trends in NIH funding rank us among the fastest growing Medical Centers in the U.S.
- Nationally, over the last ten years Emory typically has ranked in the top 20 among medical schools that receive NIH research dollars.
- Emory has ranked at or near the top of institutions for students with NIH predoctoral fellowships.
- State-of-the-art facilities and investigators.
- Beautiful campus located 6 miles east of downtown Atlanta.
Programs
The Graduate Division of Biological and Biomedical Sciences (GDBBS) offers a unique training structure for their students. All of our graduate programs are interdepartmental and are centered on broad approaches to modern biological sciences.

The Biochemistry, Cell and Developmental Biology (BCDB) program at Emory University is a cross-disciplinary training program that encourages and fosters innovative thinking and experimentation. Our faculty members are drawn from 15 departments within Emory University to provide training in Biochemistry, Cell Biology, Developmental Biology, Molecular Biology, Structural Biology, Cancer Biology, and allied areas of research. The program uses formalized training in scientific research, presentation, writing, hypothesis design, and teaching to enable students to integrate multiple biological disciplines. Our students graduate as well-rounded biomedical research scientists who are highly competitive in a number of different career paths. Whether your goal is pure basic science or translational research we offer research opportunities that will enable you to impact human health and our understanding of our world.

The Program in Cancer Biology (CB) provides outstanding training opportunities in every aspect of cancer research, from basic to translational research. This includes molecular and cellular biology, genetics and epigenetics, signal transduction, genetic engineering, nanotechnologies, and many other disciplines used to understand the development and progression of cancer.

Today, the opportunities in the fields of genetics and molecular biology are amazing. The wealth of genetic information and the potential to use this information for developing novel medical therapies and diagnostic procedures is unprecedented. With this in mind, the goal and philosophy of the Genetics and Molecular Biology (GMB) graduate training program is to provide the best training in a core area of genetics and molecular biology while at the same time providing broad-based training in the related disciplines of biochemistry, cell biology, statistics, and bioinformatics. In addition to coursework, first-year students participate in eight-week research rotations in faculty laboratories of their choice. These rotations provide the basis for selecting the area of genetics in which the student will become an expert. Seminar courses occurring each semester focus on current topics in genetics and molecular biology and are presented by investigators within and outside of Emory. We also believe that strong presentation and communication skills are critical to becoming a top-notch scientist. As such, GMB students present periodic progress reports on their own research to the assembled program. This combined training is designed to allow students to develop into scientific leaders in the 21st century.

The Immunology and Molecular Pathogenesis (IMP) at Emory University is part of the broader Graduate Division of Biological and Biomedical Sciences at Emory that offers research-intensive training programs leading to the PhD degree. The IMP program offers interdisciplinary training in molecular and cellular immunology and the role of the immune system in the pathogenesis of infectious disease. Faculty members are affiliated with basic science and clinical departments in the School of Medicine, Emory Vaccine Center, Emory National Primate Research Center, as well as the adjacent U.S. Centers for Disease Control and Prevention. Explore this site to meet our faculty and learn about their research, meet our students, and get an idea of what the IMP graduate experience is all about.

The Program in Microbiology and Molecular Genetics (MMG) provides training in the study of microorganisms as well as in the use of microbial models to investigate basic problems in molecular genetics. The program is designed not only for students interested in academic careers in teaching and research, but also for those interested in careers in related aspects of medicine and industry. Research training is offered in bacterial genetics and physiology, microbial development, molecular biology of viruses and bacterial pathogens, mechanisms of bacterial and viral pathogenesis, molecular biology of gene regulation, antibiotic resistance, antiviral and vaccine development.

The Molecular and Systems Pharmacology (MSP) graduate program offers broad training in the biomedical sciences for students interested in learning how the drugs of today work and how the novel therapeutics of tomorrow can be developed. PhD training in the Emory MSP graduate program prepares students for successful careers in the biotechnology and pharmaceutical industries as well as in academic research, teaching, government research, patent law, and other disciplines that depend upon knowledge of fundamental pharmacological principles.

Neuroscience research at Emory has grown dramatically in the last decade with the recruitment of many renowned scientists. The broad spectrum of research expertise in cellular, molecular, behavioral, developmental, and systems neuroscience provides our students a unique environment in which to pursue their graduate education. The Neuroscience (NS) program includes over 120 neuroscientists drawn from more than 20 departments the Emory College of Arts and Sciences, Emory School of Medicine, Rollins School of Public Health, as well as collaborators at Georgia Institute of Technology and Atlanta VA Medical Center (Atlanta VAMC). Many faculty come from the departments of Pharmacology, Neurology, Psychiatry and Behavioral Sciences, and Rehabilitation Medicine, which are ighly-ranked in research and funding. Thus, our program provides access to excellent labs focused on a wide variety of specialties within neuroscience.

Our goal is to provide the multidisciplinary training required for a successful research and teaching career. The faculty and students in the Population Biology, Ecology, and Evolution (PBEE) program pursue a broad range of research questions in a wide variety of experimental systems, ranging from bacteria to humans. One central feature unites our program: the focus on the use of quantitative methods and models during the course of our research. This theme is reflected in the design of our core curriculum and the research projects pursued by our students. Our graduate program has six main areas of inquiry:
- Bioinformatics and Biostatistics
- Biology of Species Interactions
- Disease Ecology
- Ecological and Evolutionary Modeling
- Genetics of Complex Traits
- Population and Comparative Genomics
Experience That Sets You Apart

World Class Partners
In addition to research opportunities within the basic science departments, students also have unique training opportunities unavailable anywhere else. Students can choose to work with around 360 faculty members affiliated with:
Discover the Emory Community
The resources and faculty available to our graduate students provide them with the necessary training to excel. The Division has around 400 students in various stages of graduate training and they are typically primary or co-authors on more than 200 research papers or abstracts. The training our students receive prepares them for jobs in many different career areas, including faculty and postdoctoral positions at top research universities, prestigious institutions, such as the U.S. Centers for Disease Control and Prevention and the National Institutes of Health, and positions in government and the pharmaceutical industry.
More Videos
At Emory, you’ll do more than just scientific research.
You’ll investigate, innovate, and lead.
In Emory’s Graduate Division of Biological and Biomedical Sciences (GDBBS), you’ll benefit from the perspective of interdisciplinary learning, collaborate with global research leaders, and enrich your work with the resources of a major biological research center.
"One of the things that I appreciate about our approach to graduate training at Emory is our commitment to training complete scientists who are prepared to pursue their own individualized career goals. Our goal is to help students discover and hone their personalized career goals, provide the tools and support to achieve those goals, and then create an environment for students to flourish."
—Anita H. Corbett, PhD, Samuel C. Dobbs Professor of Biology
Frequently Asked Questions
What are the general admissions requirements?
- A strong undergraduate background in the physical, biological, or behavioral sciences.
- A cumulative average of B+ or better in major science courses.
- High motivation for a career in biological or biomedical research.
- Strong letters of recommendation (three (3) are required).
- Prior research experience is highly valued.
- A thoughtfully written Statement of Purpose that includes information on why you want to attend graduate school, any research interests you may have, and details on any prior research experience, including the extent to which you were intellectually and independently involved in your research project.
- GRE scores are not required and there is no field to enter this information in the application.
- International applicants whose native language is not English must also complete the Test of English as a Foreign Language (TOEFL), or the International English Language Testing System (IELTS). For these exams, scores must be no more than two (2) years old from the date of the application.
What do admissions committees consider during the review process?
- Admissions committees consider prior research experience to be the most important factor in the application review process, followed in order by letters of recommendation from research mentors, transcripts and GPA, other relevant letters of recommendation if any, and honors and/or leadership positions.
What are the admissions statistics?
- Around 12% of the applicant pool is offered admission and approximately 40-50% enroll. (The Graduate Division typically enrolls about 70 students each year.)
How long does it take to complete the program?
- It takes approximately 6 years to complete the PhD, but the time to degree can vary among the different programs. The Laney Graduate School lists program statistics for each of their programs. The Graduate Division of Biological and Biomedical Sciences and our eight programs are listed individually.
What is the average GPA for a Biological and Biomedical Science applicant?
- Students offered admission typically have cumulative GPAs that range from around 3.0 to 4.0, and the average GPA for the incoming class is historically around 3.5.
Do you enroll for the MS degree?
- All GDBBS programs lead to the PhD degree. There are no master's degree programs offered by the GDBBS.
When are interviews held?
- Program interviews are usually held in late January through late February by invitation of the Program to which the student has applied. Interview travel expenses are paid by the Division for domestic applicants. Please see Section 9 - International Students for how international interviews are handled.
How does the interview process work?
- All of our programs invite students to campus and pay the expenses if the applicant is invited to interview. We do not pay for applicants to visit outside of the interview process. If you will be in the Atlanta area and would like to visit on your own we can try to customize a visit for you, but we would need at least 2 weeks' notice, along with a list of who you would like to meet. Faculty are generally not available during the busy admissions season, which is typically from December through February.
Can you review my material before I submit my application?
- Our office does not evaluate material for prospective applicants. Each program has an admissions committee that will review the applications that are submitted to their program.
Do I need to have received an MS degree prior to applying?
- The minimum requirement to enroll is receipt of a bachelor's degree.
Can I start in the spring?
- No, all students start in the fall semester.
Do I need to contact professors before I apply?
- You do not need to contact faculty since all students perform three rotations prior to affiliating with a faculty member. You do not need to know whom you want to work with prior to applying, but if you are interested in certain professors you can list that information in your statement of purpose.
Are applicants required to have previous research experience?
- Research experience is highly desired by the admissions committees. Research experiences can vary greatly by applicant and could range from summer experiences, to work done at your degree institution, to work performed as an employee after graduation. Research, where you are more intellectually and independently involved, are stronger experiences.
What level of financial support do you provide?
- All students who are accepted and enroll receive a competitive stipend, tuition scholarship, and health insurance. For the 2025-2026 academic year the stipend for students in GDBBS programs is $42,000.
Are teaching or laboratory assistantships required for receipt of financial aid?
- No, however, all students are required to serve as a teaching assistant for one semester, usually during their second year. This is an educational requirement of the Laney Graduate School. The primary purpose of the teaching experience is to aid students in strengthening their organization and communication skills.
What happens if I receive an external fellowship?
- Students who apply for and are awarded an external fellowship that provides at least 75% of their stipend will receive a $2,000 supplement to their stipend for the length of the award.
How does the cost of living compare at Emory?
- The cost of living in suburban Atlanta compares very favorably to other university cities, and only in rare instances is the cost of living in the Emory area higher than that of comparable universities.
Is this an umbrella program?
- All of our graduate programs are interdepartmental and are centered on broad approaches to modern biological sciences. GDBBS is not departmental based and not an umbrella program. Applicants apply to and are accepted by a specific program that fits their broad interests. Students work with faculty from many different departments, which provides a truly interdisciplinary training experience. Most students graduate from the program to which they are admitted, but for those whose research interests change, the GDBBS provides the flexibility by allowing the student to change programs after the first year, or work with another GDBBS faculty member in a different program. This provides the flexibility of an umbrella program while giving the student better mentoring of program-based admissions.
Can I apply to more than one program?
- You may apply to more than one program by submitting complete applications for each program, including letters of recommendation.
Can I transfer credits from another program?
- Transfer of Ph.D. credits is entirely up to the program to which you are admitted and typically occurs around the time of matriculation. The program will review your transcript and if there are any courses that are similar to any of the courses in the curriculum, then they may consider transferring those credits if you are accepted into the program.
When is the application available?
- Our online application should be available by early September each year. The deadline date for submission is 11:59 p.m. Pacific Standard Time on December 1st.
Do you offer application fee waivers?
- The Laney Graduate School offers two general types of fee waivers: 1) based on participation in certain graduate study preparation programs, and 2) for financial need. Information can be found at on the Admissions Application page under the "Application Fee" section.
What do admissions committees consider during the review process?
- Admissions committees consider prior research experience to be the most important factor in the application review process, followed in order by letters of recommendation from research mentors, transcripts and GPA, other relevant letters of recommendation if any, and honors and/or leadership positions.
- The Statement of Purpose provides an opportunity for you to convey to the admissions committee how your academic and research experiences have motivated and prepared you for doctoral studies in the biosciences. You should express why you have chosen your particular field of interest, discuss your tentative plans for graduate research, as well as your proposed career plans. Describe your involvement in relevant advanced courses and research projects, and describe the extent to which you were intellectually and independently involved in your research. It is helpful to include a resume and cite any publications that resulted in whole or in part by your work. Keep in mind that this is not a test of your creative writing skills. Statements should contain substantive, applicable information that will assist the admissions committee in determining whether or not you are well-suited for doctoral study. Committees will be searching for students who demonstrate a firm commitment to research and who express a genuine interest in the proposed field of scientific study. There are no word or page limits, however, we recommend that the statement of purpose be no longer than two pages double-spaced. This is only a recommendation, and your statement of purpose can be longer, if needed.
How many letters of recommendation are required?
- Three letters of recommendation are required for your application to be complete. There is space on the application to enter an optional fourth letter.
When are letters of recommendation due?
- Letters of recommendation are a very important part of your application. It is highly recommended that you complete this section of the application as early as possible so that you can give your letter writers as much time as possible to complete and submit their letter of recommendation. If you wait to complete this section until shortly before you submit your application the admissions committee may not receive the letters of recommendation in time to consider them during their review process, which would place your application at a disadvantage. The deadline to receive the letters of recommendation is December 1.
GRE scores are not required, but can I still submit GRE scores with my application?
- GRE scores are not required by any of the Programs in the Graduate Division of Biological and Biomedical Sciences, and, therefore, will not be considered during the admissions process.
Can application material arrive after the deadline date?
- All material is supposed to arrive by the December 1 deadline date. We will continue to accept application material after the deadline date, however, after December 1 the programs will be actively reviewing applications and making decisions and the later support material arrives the more of a negative impact it will have on your application.
Can I send material by mail?
- We specifically ask that applicants not send us any material in the mail. The rare exception can be made for letters of recommendation, but only when the letter writer cannot use the online system to submit the letter or the applicant is sending letters by mail using Interfolio. There is a processing delay when letters are received outside of the online system.
Who do I contact if I need help with the application?
- If you need additional assistance, please email lgsadmissions@emory.edu.
How many letters of recommendation are required?
- Three letters of recommendation are required for your application to be complete. There is space on the application to enter an optional fourth letter.
Can I submit a paper letter of recommendation?
- Unless the faculty member is unable to use a computer to complete the recommendation process we strongly recommend asking them to use the online recommendation system. The online application is set up so that all of the material can be submitted online. The online system is set up in such a way that the processing of the paper recommendation letter will cause a delay in the processing of your application, as it will have to be handled as a separate form rather than as part of the whole application (any online recommendations received are automatically bundled with the rest of your application file).
How can I send a reminder to a recommender?
- Using the online system, applicants can send an email to their recommenders, delete a recommender and add a different one, or add a fourth recommender. We must receive three letters of recommendation for your application to be complete.
How do I submit a letter of recommendation using Interfolio?
- In some cases Interfolio has uploaded the recommendations, and in such cases they provided the applicant with the email address that they should use in the application. If Interfolio does not provide an email address, then you can send the letters to Kathy Smith at kathy.smith@emory.edu or by mail.
How do I enter my GPA?
- The application asks for you to enter your GPA and GPA scale. There is no need to translate your GPA to a 4.0 scale. If your school does not provide a GPA, as is the case in a few schools, enter a GPA of 0.0 and a scale of 0.0, and this will let us know that your school does not assign GPAs.
How should I provide my unofficial transcripts for the application?
- The preferred method is for you to get an official copy of your transcript from the Registrar's office, scan it as a single PDF, then upload it to your application. However, if the unofficial transcript that you can print from your school's student information system is organized and easy to read then it will be acceptable to use the copy printed from the web. In our experience, some of the copies printed from student web interfaces are very difficult to read, and hence we prefer copies from the Registrar's office.
I uploaded my transcripts to my application. Do I need to send official transcripts as well?
- The admissions committee uses the unofficial transcripts that applicants upload as part of their application during their review process. Only students who are accepted and enroll need to provide official degree granting transcripts, and we specifically ask that applicants not send us material in the mail.
Are there special instructions for submitting international transcripts?
- Degrees and transcripts from international institutions often differ from those in the United States. We recommend that applicants with degrees from international universities submit a course-by-course educational credential evaluation of each international transcript so that the Emory admissions committee will fully understand your educational background and academic preparation.
- Course-by-course evaluations help the faculty who review applications compare the education at an international institution to a similar education at a U.S. university. Among other things, evaluations show course titles along with grades and credit hours translated into U.S. equivalents. Since university credit and grading systems vary a great deal across the world, these documents help ensure that international credentials are assessed appropriately.
- We do not require that you submit credential evaluations. Your application will be considered complete as long as it contains transcripts, with translations as needed.
- If you decide to submit a credential evaluation, please keep the following in mind:
- The process of requesting and receiving credential evaluations adds time to your application preparation. Be sure to start early, so all your materials will arrive with your application by the application deadline.
- We accept credential evaluations from Educational Credential Evaluators, Educational Perspectives, and World Education Services.
- Reports from Educational Perspectives can be requested and attached to your application in our application form, through a service called CertiFile. If you choose to do this, the application will guide you through the steps the process is explained in the Education section of our application if you enter information for an international institution. Note that an evaluation you request through our application will be yours to use for other applications as well.
- Reports from Educational Credential Evaluations or World Education Services can be attached to your application through the transcript upload field associated with the educational institution you enter information about. If you upload the credential evaluation(s) yourself, remember to include with the evaluation report the transcript that was evaluated, along with the translation if appropriate, all in one file.
How do I upload transcripts that are more than one page?
- Transcripts need to be uploaded as one complete file, so applicants will need to combine all of the pages into one file before uploading.
Do I need to provide transcripts for all of the schools I attended?
- If you attended a school and had your course(s) transferred to your degree institution and that transcript lists the course, grade, and credit hours you do not need to submit a separate transcript. If you list that school as a separate entry the application system will require that you upload a transcript.
Can I submit updated versions of application material (e.g., CV, statement of purpose, transcripts)?
- We are unable to respond to students requests to upload different material to their application. Our office does not remove or add any document to your application once it has been submitted, so please take care to upload the correct documents before you submit your application.
Is there a section where I can see what is missing in my application?
- The online application is set up so that all required material must be completed/uploaded before the applicant can submit the application. The two exceptions are the official scores (the admissions committee will start the review process with your unofficial scores) and the letters of recommendation (which you can track in the activity center in CollegeNET).
How do I find out the status of my application?
- Once the program has made a final decision on your application you will be notified. We do not post decisions online, and each applicant will receive an email with the final status of their application once that decision has been made. All decisions are finalized by April 15th.
How do I find out if all of the interview invitations have been extended?
- The programs handle their own review process. The admissions committee starts reviewing applications shortly after the December 1 deadline date and then start to extend interview invitations. Each program will also typically maintain a healthy waitlist and programs will sometimes extend additional interview invitations later in the process. Each applicant will receive an email with the final decision that was made on their application, and until you receive that email your application is still under consideration.
Are international students with a bachelor's degree eligible to apply for this program?
- All applicants who are offered admission and enroll must have received a minimum of a bachelor's degree prior to matriculation in one of our PhD Programs.
Do international students who are admitted to the program receive the same financial support as U.S. citizens?
- We provide financial support, including a tuition scholarship, health insurance and stipend ($38,404 for the 2024-2025 academic year) to all students who accept our offer of admission and enroll.
Do you offer application fee waivers for international applicants?
- The Laney Graduate School offers fee waivers based on financial need. Information can be found on the Admissions-Application page under the "Application Fee Waivers" section.
How many international students apply and are accepted?
- In a typical admissions cycle about 35% of the applications are from international students. Around 11% of the entering class is international.
Can the TOEFL requirement be waived?
The TOEFL exam is waived if the applicant will receive a BS or MS degree from an institution where English is the language of instruction. There is a slight distinction:
- If you will be receiving your BS or MS degree from a US institution (or another English-speaking country), then the TOEFL is automatically waived and no documentation is required.
- If you received your education outside of the US but from an institution where English is the language of instruction, we will waive the TOEFL requirement. In such cases, the applicant has to send Kathy Smith (Kathy.Smith@emory.edu) an email stating that their school's language of instruction is English.
NOTE: The IELTS can substitute for the TOEFL exam.
How are interviews usually organized for international students?
- This varies by program and can typically be handled 1) via Skype; 2) the program may pay a portion of the applicant's international airfare to Atlanta; or 3) the program may pay the applicant's airfare from a location in the United States to Atlanta (and the applicant pays the costs to the United States).
Is there a minimum score for the TOEFL exam?
- We have no set minimums and the admissions committee considers all aspects of application when making their decision. The recommended score is 100, and admitted applicants usually have a wide range of scores.
Are there special instructions for submitting international transcripts?
- Degrees and transcripts from international institutions often differ from those in the United States. We recommend that applicants with degrees from international universities submit a course-by-course educational credential evaluation of each international transcript so that the Emory admissions committee will fully understand your educational background and academic preparation.
- Course-by-course evaluations help the faculty who review applications compare the education at an international institution to a similar education at a U.S. university. Among other things, evaluations show course titles along with grades and credit hours translated into U.S. equivalents. Since university credit and grading systems vary a great deal across the world, these documents help ensure that international credentials are assessed appropriately.
- We do not require that you submit credential evaluations. Your application will be considered complete as long as it contains transcripts, with translations as needed.
- If you decide to submit a credential evaluation, please keep the following in mind:
- The process of requesting and receiving credential evaluations adds time to your application preparation. Be sure to start early, so all your materials will arrive with your application by the application deadline.
- We accept credential evaluations from any evaluator affiliated with NACES, The National Association of Credential Evaluation Services. The most common ones are World Education Services, Educational Credential Evaluators, and Educational Perspectives.
- Reports from Educational Perspectives can be requested and attached to your application in our application form, through a service called CertiFile. If you choose to do this, the application will guide you through the steps the process is explained in the Education section of our application if you enter information for an international institution. Note that an evaluation you request through our application will be yours to use for other applications as well.
- Reports from Educational Credential Evaluations or World Education Services can be attached to your application through the transcript upload field associated with the educational institution you enter information about. If you upload the credential evaluation(s) yourself, remember to include with the evaluation report the transcript that was evaluated, along with the translation if appropriate, all in one file.

Focused Career Development
The Graduate Division of Biological and Biomedical Sciences and Laney Graduate School have a strong focus on career development. Our Professional Development and Career Planning program helps position our well-rounded and competitive candidates for a wide variety of fields. Career resources include:
- Grant Writing
- Strategic Communication
- Career Exploration
- Career Resources
- Professional Development Support Funds

Diversity is Valued
The Graduate Division of Biological and Biomedical Sciences (GDBBS) has a proven track record of enrolling and graduating underrepresented students, particularly African American students. Since 2021, Diverse Education's Top 100 Degree producers has ranked the GDBBS as 1st and 9th nationally for graduating African American students from our Ph.D. programs.
Emory has received a Higher Education Excellence in Diversity (HEED) Award for the third consecutive year by “Insight Into Diversity” magazine, the oldest and largest diversity-focused publication in higher education. The magazine also named the university a Diversity Champion, a distinction reserved for the top tier of winners. HEED Awards recognize colleges and universities that demonstrate an outstanding commitment to diversity and inclusion.